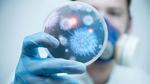
ما هي الأمراض التي تسببها البكتيريا

ما هي الأمراض التي تسببها البكتيريا
البكتيريايُمكن تعريف البكتيريا (بالإنجليزية: Bacteria) على أنّها كائنات مجهرية أحادية الخلية، تتميز بحجمها الصغير؛ بحيث لا تُرى بالعين المُجرّدة، ويعيش هذا
البكتيريا
يُمكن تعريف البكتيريا (بالإنجليزية: Bacteria) على أنّها كائنات مجهرية أحادية الخلية، تتميز بحجمها الصغير؛ بحيث لا تُرى بالعين المُجرّدة، ويعيش هذا النّوع من الكائنات الحيّة في بيئات متنوعة، فبعضها قد يوجد داخل جسم الإنسان، بينما بعضها الآخر يوجد خارجه، وممّا لا شك فيه أنّ هناك أنواعاً مختلفة من البكتيريا؛ والتي قد يكون بعضُها مفيداً للإنسان، بينما بعضُها الآخر ضار له، وتمتاز البكتيريا بأنّها قوية ومُعقدة؛ بما يُمَكّنها من البقاء والعيش في الظروف القاسية، وبعضها قد يمتلك تركيباتٍ خاصّة تُساعده على الاستمرار والتكيّف مع هذه الظروف.[1]
الأمراض التي تسببها البكتيريا
هُناك العديد من أنواع البكتيريا التي قد تُسبّب أمراضاً للإنسان، وتجدر الإشارة إلى أنّ شدة الإصابة بالعدوى البكتيرية تعتمد على العديد من الجوانب؛ بما في ذلك نوع البكتيريا المُسبّبة للعدوى، والصحّة العامّة للشخص، والعوامل التي من شأنها تعزيز العدوى أو تخفيفها، وفيما يأتي بيان لأبرز أنواع البكتيريا التي قد تُصيب الإنسان والأمراض المُرتبطة بها:[2][3]
- السالمونيلا: (بالإنجليزية: Salmonella)، يؤدي هذا النّوع من البكتيريا إلى المُعاناة من التسمّم الغذائي، وغالباً ما تنتج هذه الحالة من الأنواع غير التيفية من بكتيريا السالمونيلا، التي توجد في الأجزاء المعوية للبشر والحيوانات.
- المتفطّرة السلّية: (بالإنجليزية: Mycobacterium tuberculosis)، تؤدي هذه البكتيريا إلى المُعاناة من مرض السلّ، وقد تؤثر بشكلٍ خطير في الأجهزة المُختلفة من جسم الإنسان؛ وبالأخص الرئتين.
- المكورات العنقودية الذهبية المقاومة للميثيسيلين: (بالإنجليزية: Methicillin-resistant Staphylococcus aureus)، واختصاراً (MRSA)، تُمثل أحد أشكال البكتيريا المُقاومة للمضادات الحيوية، والتي قد تكون مُميتة، خاصّة عند إصابة الأشخاص الذين يُعانون من ضعف جهاز المناعة بها.
- المطثية العسيرة: (بالإنجليزية: Clostridium difficile)، وهي تُمثل أحد أشكال البكتيريا التي توجد في الأمعاء بشكلٍ طبيعي، ولكن عند تعرّضها لظروفٍ مُعينة تُساهم في فرط نموّها؛ كما هو الحال عند الإفراط في تناول المضادات الحيوية، فإنّ ذلك قد يتسبّب بالمُعاناة من الأمراض المعدية المعوية.
- الملوية البوابية: (بالإنجليزية: Helicobacter pylori)، يرتبط هذا النّوع من البكتيريا بالإصابة بأمراض مُختلفة في المعدة؛ بما في ذلك قرحة المعدة والتهاب المعدة المزمن.
- النيسريّة البنيّة: (بالإنجليزية: Neisseria gonorrhoeae)، تؤدي إلى الإصابة بمرض السيلان الذي ينتقل من شخص إلى آخر عبر الاتّصال الجنسيّ.
- المكورات العنقودية الذهبية: (بالإنجليزية: Staphylococcus aureus)، يؤدي هذا النّوع من البكتيريا إلى الإصابة بالحالات الصحّية والأمراض المُختلفة؛ بما في ذلك الدمامل، والخُراجات (بالإنجليزية: Abscess)، والتهاب النسيج الخلوي (بالإنجليزية: Cellulitis)، وعدوى الجروح، ومتلازمة الصدمة التسمّمية (بالإنجليزية: Toxic shock syndrome)، بالإضافة إلى الالتهاب الرئوي (بالإنجليزية: Pneumonia) والتسمّم الغذائي.
- المكورات العقدية: (بالإنجليزية: Streptococcus)، قد يؤدي هذا النّوع من البكتيريا إلى الإصابة بأنواع مختلفة من الأمراض؛ وتتضمن الالتهاب الرئوي، والتهاب السحايا (بالإنجليزية: Meningitis)، وعدوى الأذن، والتهاب الحلق العقدي (بالإنجليزية: Strep throat).
وتجدر الإشارة إلى أنّ هُناك العديد من الأمراض الأخرى التي قد يُعزى حدوثها إلى العدوى البكتيرية في كثيرٍ من الأحيان؛ بما في ذلك التهاب المهبل البكتيري (بالإنجليزية: Bacterial vaginosis)، وتتمثل أعراض هذا الالتهاب بالمُعاناة من الحكّة، وزيادة الإفرازات، إضافة إلى الشعور بالألم عند التبوّل، ويجدر التنبيه إلى ضرورة مراجعة الطبيب في حالات الاشتباه بإصابة الشخص بأيّ نوعٍ من العدوى البكتيرية، أو في حال ظهور أعراضٍ قد تدلّ على ذلك كزيادة درجة الحرارة، والتعب أو عدم الاستجابة، نظراً لكون هذا النّوع من العدوى قد يتسبّب في المُعاناة من مُضاعفاتٍ خطيرة؛ كمتلازمة الصدمة التسمّمية، أو الفشل الكلوي، أو تجرثم الدم (بالإنجليزية: Bacteremia).[2][3]
الوقاية من العدوى البكتيرية
بشكلٍ عامّ قد تنتقل العوامل المُعدية والتي تتضمن البكتيريا عبر الوسائل المُختلفة؛ بما في ذلك الاتّصال عبر الجلد أو التعرّض لإصابات، أو استنشاق الجراثيم الموجودة في الجو، أو تناول الأطعمة والمشروبات الملوثة، أو التعرّض للدغات الحشرات، أو عبر الاتّصال الجنسيّ، وتجدر الإشارة إلى أنّ هنالك العديد من النّصائح والإرشادات التي يُنصح باتّباعها لتقليل احتمالية انتقال العدوى من شخصٍ إلى آخر، نذكر منها ما يأتي:[4]
- غسل اليدين باستمرار: خاصّة قبل وبعد إعداد الطعام، وقبل تناول الطعام، وبعد استخدام الحمام، مع الحرص على تجنّب لمس الأجزاء المختلفة من الجسم باستخدام اليدين؛ وبخاصّة الأنف، والعيون، والفم، نظراً لكون ذلك قد يتسبّب في دخول الجراثيم إلى جسم الإنسان.
- الحصول على المطاعيم المُناسبة: يُساهم ذلك في تقليل احتمالية الإصابة بالعديد من الأمراض، وتجدر الإشارة إلى ضرورة استشارة الطبيب قبل السفر؛ فهُناك أنواع من المطاعيم التي يُنصح بأخذها في هذه الحالة تجنّباً للإصابة بالعدوى من الخارج؛ بما في ذلك المطاعيم المُخصّصة للوقاية من الإصابة بالحمّى الصفراء، أو الكوليرا (بالإنجليزية: Cholera)، أو الحمّى التيفية (بالإنجليزية: Typhoid fever)، أو الالتهاب الكبدي أ أو ب.
- مُلازمة المنزل في فترات المرض: يُنصح بالبقاء في المنزل، وعدم الذهاب إلى العمل أو المدرسة في حالات المُعاناة من العدوى البكتيرية، خاصّةً عند ظهور أعراضٍ مُعينة؛ كالتقيؤ، أو الإسهال، أو الحمّى.
- تحضير الطعام بشكلٍ آمن: يُنصح بالحرص على استخدام معدات طبخ نظيفة عند تحضير الطّعام، والحرص على حفظ الطّعام وطهيه على درجات حرارة مُناسبة، وفيما يتعلّق بالأطعمة المطبوخة؛ فيُنصح بتجنّب إبقائها على درجة حرارة الغرفة لفتراتٍ طويلة من الزمن؛ إذ يجدُر بالشخص حفظها في الثلاجة بطريقة مُناسبة.
- الابتعاد عن العلاقات الجنسية غير الشرعية: فعدا عن كونها مُنافية للشريعة الإسلامية، فهي تُعتبر سبباً في الإصابة بالأمراض المنقولة جنسيّاً.
- تجنّب مشاركة الأدوات الشخصية مع الآخرين: وبخاصّة أدوات الحلاقة، والمشط، وفرشاة الأسنان، إضافة إلى الأواني والأكواب التي يتمّ استخدامها عند تناول المأكولات والمشروبات.
المراجع
- ↑ "bacteria", www.healthline.com, Retrieved 23-11-2018. Edited.
- ^ أ ب "Types and Treatment of Bacterial Infection", www.verywellhealth.com, Retrieved 23-11-2018. Edited.
- ^ أ ب "Bacterial Diseases", www.healthgrades.com, Retrieved 23-11-2018. Edited.
- ↑ "Infectious diseases", www.mayoclinic.org, Retrieved 23-11-2018. Edited.
المقال السابق: ما هي أعراض المرارة وعلاجها
المقال التالي: ما هي أفضل الفواكه للحامل
ما هي الأمراض التي تسببها البكتيريا: رأيكم يهمنا

0.0 / 5
0 تقييم
